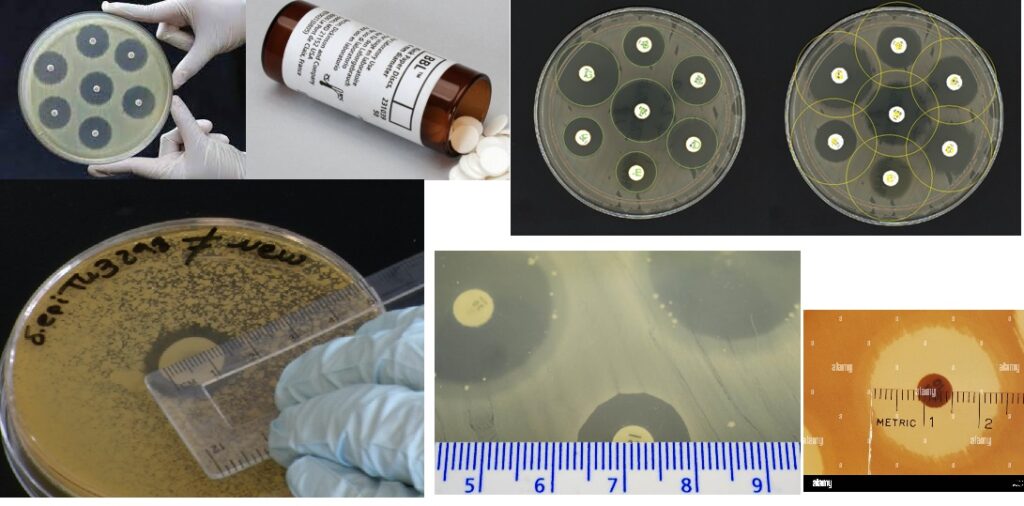

Sterile Discs
Sterile discs can be used for testing antibiotic susceptibility testing by loading antibiotic of choice.
Appearance:
Sterile filter paper discs of 6mm diameter
Cultural response:
Sterility of the discs checked for 14 days in Alternative Thioglycollate Medium (M010) at 30-35°C and
Soyabean Casein Digest Medium (M011) at 20-25°C.
| Sample | Results in Alternative Thioglycollate Medium (M010) | Results in Soyabean Casein Digest – Medium (M011) |
| Test | Clear, No growth observed | Clear, No growth observed |
| Negative Control | Clear, No growth observed | Clear, No growth observed |
| Positive control | Luxuriant growth observed | Luxuriant growth observed |
Storage and Shelf-life:
Store at 2°C to 8°C. Use before expiry date on the label.
A systemic gram positive ring device, suited towards Gram Positive organisms, carrying 8 antibiotic impregnated tips allowing the simultaneous application of the equivalent individual antimicrobial susceptibility test discs.
A paper ring, 65mm in diameter, with eight projecting arms. Each arm is impregnated with a different antibiotic identified using a letter from the key.
- Pack of 10 Mast Rings
Antibiotics include:
- Chloramphenicol – 25µg
- Erythromycin – 5µg
- Fusidic Acid – 10µg
- Oxacillin – 10µg
- Novobiocin – 5µg
- Penicillin G – 1 unit
- Streptomycin – 10µg
- Tetracycline – 25µg
Learning Outcomes
- GCSE & A-Level Biology: Microbiology – Antibiotic Resistance
- Zones of inhibition can sometimes be rather large when using Mast Rings. The antibiotic discs could be trimmed off and applied 3-4 at a time on a single bacterial plate to prevent the zones from overlapping.
Top Tips
- Zones of inhibition can sometimes be rather large when using Mast Rings. The antibiotic discs could be trimmed off and applied 3-4 at a time on a single bacterial plate to prevent the zones from overlapping.
How do antibiotic assay rings work?
Antibiotic resistance tests: Bacteria are streaked on dishes with white disks, each impregnated with a different antibiotic. Clear rings, such as those on the left, show that bacteria have not grown—indicating that these bacteria are not resistant.
How do you test for antibacterial resistance?
The most common types of tests are listed below.
- Blood culture. A health care professional will take a blood sample from a vein in your arm, using a small needle. …
- Urine culture. You will provide a sterile sample of urine in a cup, as instructed by your health care provider.
- Wound culture. …
- Sputum culture. …
- Throat culture.
What are the classification of bacteria and antibiotics?
Learning Objectives. Antibiotics can be divided into two classes based on their mechanism of action. Bactericidal antibiotics kill bacteria; bacteriostatic antibiotics inhibit their growth or reproduction. One way that bactericidal antibodies kill bacteria is by inhibiting cell wall synthesis.
What are two methods used to determine antibiotic susceptibility?
Two methods of bacterial culture and antibiotic susceptibility testing are commonly used in veterinary medicine: (1) the disk diffusion technique and (2) the broth dilution technique. Both methods identify the infecting pathogen and the antibiotics that are likely to inhibit its growth.

